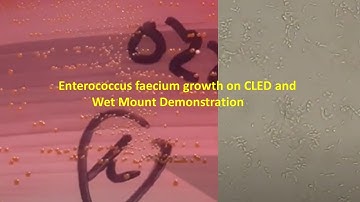
Enterococcus faecium Colony Morphology and Microscopy
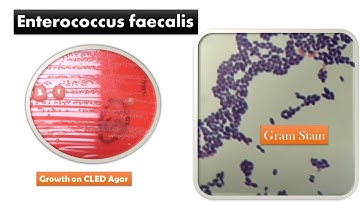
Enterococcus faecalis Colony Morphology and Gram Staining

⬇ DOWNLOAD NOW
Kalau muncul iklan pop-up, tutup lalu klik tombol kembali
Download lagu Enterococcus faecalis colony morphology on CLED medium secara gratis hanya untuk keperluan promosi. Dukung artis favorit kamu dengan membeli musik original di iTunes atau platform resmi lainnya.
Enterococcus faecium Colony Morphology and Microscopy
Enterococcus faecium Colony Morphology and Microscopy
 Enterococcus faecalis Colony Morphology on CLED Agar
Enterococcus faecalis Colony Morphology on CLED Agar
 Enterococcus (E. Faecalis & E. Faecium)
Enterococcus (E. Faecalis & E. Faecium)
 Enterococcus durans Colony Morphology on CLED Agar
Enterococcus durans Colony Morphology on CLED Agar
 Enterococcus- causes, symptoms, diagnosis, treatment, pathology
Enterococcus- causes, symptoms, diagnosis, treatment, pathology
 Enterococcus faecium Colony characteristics on CLED agar
Enterococcus faecium Colony characteristics on CLED agar
Enterococcus faecalis Colony Morphology and Gram Staining
Enterococcus faecalis Colony Morphology and Gram Staining
 Colony Morphology, Wet Mount Examination, and Gram Staining of Enterococcus faecalis
Colony Morphology, Wet Mount Examination, and Gram Staining of Enterococcus faecalis